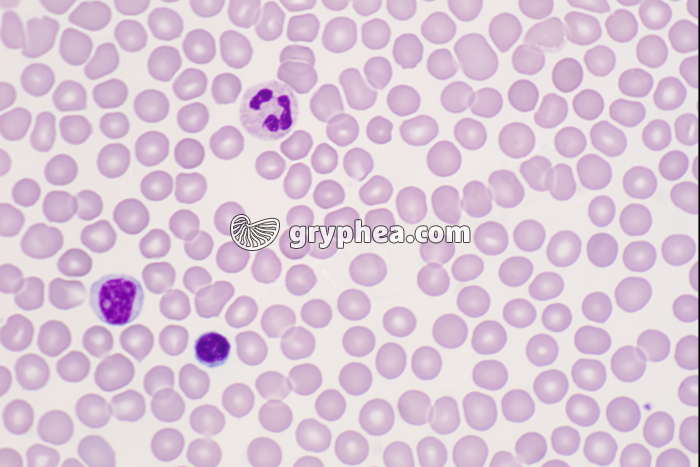
Sang humain x250 - gryphea.com

1 crédit = 6.00€ TTC
(Hors pack)
si vous êtes enseignant, le site gryphea.org a été conçu spécialement pour vous !
Chez les Vertébrés, le sang est un liquide biologique vital qui circule dans un système clos, le système circulatoire (vaisseaux et capillaires sanguins), sous l’action d’un muscle creux à fonctionnement automatique, le coeur. Ce fluide rouge est composé en grande partie d’un liquide complexe, le plasma, de cellules sanguines très nombreuses et de très petite taille, les globules rouges, qui confèrent au sang sa couleur particulière, ainsi que de cellules à rôle immunitaire, les globules blancs.
Outre les cellules sanguines, le sang assure le transport des éléments nutritifs fournis par l’alimentation, libérés ou synthétisés par certains organes, les gaz respiratoires (O2 et CO2), les déchets métaboliques, ainsi que les molécules du système immunitaire et les molécules hormonales. Les éléments figurés du sang (cellules) sont formés en permanence au niveau de la moelle osseuse (hématopoïèse).
Chez les mammifères, les[...]
La suite du commentaire est réservée aux inscrits, créez un compte gratuitement.